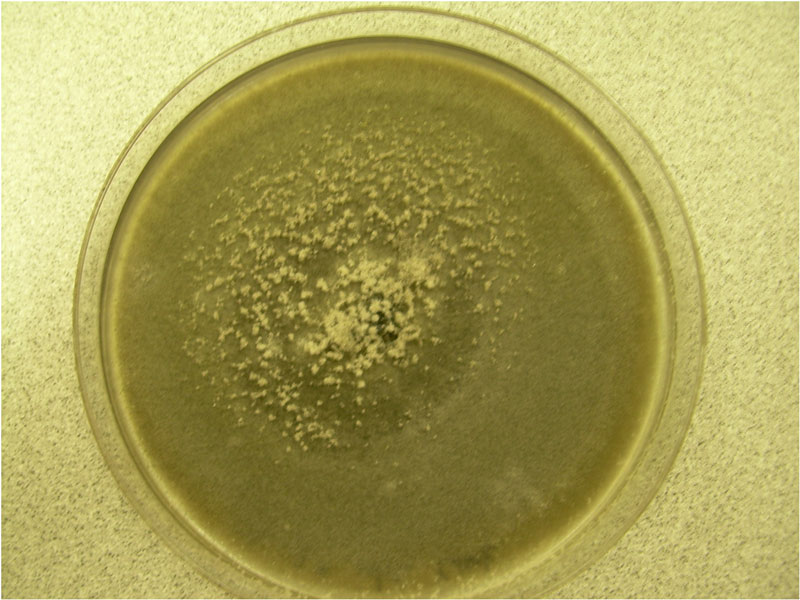

Preuss (1851)
What is Ulocladium?
The genus Ulocladium represents asexually reproducing saprophytic fungi, belonging to the family Pleosporaceae. These fungi mainly dissolve plant organic matter, and can often be found on substrates such as plant debris, lumber, paper, and water-damaged building materials. Certain species are plant pathogens and frequent food contaminants. Ulocladium spores are airborne allergens, and certain species are reported as opportunistic human pathogens [1].
What does Ulocladium look like?

Ulocladium spp. colonies are generally 60 mm (2.3 inches) in diameter, densely tufted, dark olive to very dark grey, with a bluish-black reverse (Fig. 1). They reproduce asexually through the formation of conidia on dark, granulated conidiophores. Conidia are roughly spherical to ellipsoidal, 9–12 µm in diam, usually with four or more septa (occasionally single-celled) (Fig. 2) [1,2].

Ulocladium ecology
Ulocladium spp. are widely distributed saprophytic molds, found in soil, wood, and decaying plants. They can also infect living plants with plant pathogens and spoil some food items, often nuts, beans, and cereals. A meta-analysis study revealed that the presence of Ulocladium spp. is frequent and outdoors, being identified in 42% of the 51 studies compiled. Ulocladium spp. colonies will grow on temperatures ranging from 5–34 °C (41–93 °F) and requires moderately high water activity to grow aw= 0.89–0.90 [1–3].
Ulocladium taxonomy and species
The genus Ulocladium was originally erected by Preuss in 1851 with U. botrytis as the type species [4]. Species of this genus are represented by dematiaceous phaedictyosporic (pigmented) molds with obovoid conidia. Genetically related genera are the Alternaria and Stemphylium, which can be distinguished microscopically by the spore shape. Ulocladium conidia are narrower at the base and can be pointed at one end, those of Stemphylium have rounded ends and are more or less longitudinally symmetrical, while Alternaria produces club-shaped conidia [5].
Ulocladium indoor growth
Indoors, Ulocladium sp. has been isolated from water-damaged building materials, and substrates such as paper, and textiles fibers. With the present excess indoor humidity, Ulocladium has been found on painted surfaces, and tapestry. U. chartarum is one of the constituents of house dust and mattress dust and can be also found in ventilation ducts and domestic air conditioners. In one study U. chartarum and U. oudemansii were found to be the fourth most prevalent fungus in 23 mold-infected public buildings in Denmark. This can contribute to overall bad air quality as Ulocladium spp. can produce volatile metabolites when growing on synthetic medium [2,6,7].
What are Ulocladium health problems?
Ulocladium fungi mostly cause opportunistic infections in immunocompromised individuals. Ulocladium spp. has been reported in some cases of subcutaneous, cutaneous, and nail infections, due to weakened immune systems. One case of cutaneous mycosis caused by U. chartarum was reported in a heart transplant recipient.
However, their spores are known allergens. U. botrytis is regarded as a source of home allergen sensitization and is used as a sample for skin-prick tests for mold and work-related allergens. This is because U. botrytis produces two main allergens, one of which is the “Alt a 1” that is also contained in Alternaria. Symptoms of allergies caused by this mold are similar to the symptoms caused by compatible with rhinitis and asthma [8,9]. Studies consider Ulocladium, Alternaria, and Stemphylium genera, as one of the most common mold allergens in the US [2].
How to remove Ulocladium mold?
Ulocladium spores are ubiquitous in outside environments, so there is little chance of avoiding exposure to it. However, if this mold invades building material, or spreads somewhere else in the household, prolonged exposure may cause adverse health effects.
Removing mold on your own is generally considered risky, as besides exposing yourself to dangerous chemical fumes, finding all potential sources of contamination is very difficult.
We at Mold Busters are dedicated and specialized in measuring air quality, locating and completely removing all household mold contamination, so contact us and book an inspection today.

Did you know?
Only 11% of tested bedrooms in Canada didn’t have any mold type present?! Find out more exciting mold stats and facts on our mold statistics page.
References
- Runa, F., Park, M. S., & Pryor, B. M. (2009). Ulocladium systematics revisited: phylogeny and taxonomic status. Mycological progress, 8(1), 35-47.
- Ulocladium chartarum | Mould Compendium | INSPQ
https://www.inspq.qc.ca/ - Srinivasa, N., Nayan, D. G., Basavaraj, K., Kumar, J., & Raghavendra, B. T. Ulocladium atrum: A potential biological control agent.
- Preuss, C. G. T. (1851). Die Pilze Deutschlands. Heft. 30. Jacob Sturm’s Deutschlands Flora, Abt, 3, 73-96.
- Runa, F., Park, M. S., & Pryor, B. M. (2009). Ulocladium systematics revisited: phylogeny and taxonomic status. Mycological progress, 8(1), 35-47.
- Pieckova, E. and Wilkins, K. (2004). Airway toxicity of house dust and its fungal composition. Ann Agric.Environ Med. 11[1], 67-73.
- Duran, M. T., Del, Pozo J., Yebra, M. T., Crespo, M. G., Paniagua, M. J., Cabezon, M. A., and Guarro, J. (2003). Cutaneous infection caused by Ulocladium chartarum in a heart transplant recipient: case report and review. Acta Derm.Venereol. 83[3], 218-221.
- Moreno, A., Pineda, F., Alcover, J., Rodríguez, D., Palacios, R., & Martínez-Naves, E. (2016). Orthologous allergens and diagnostic utility of major allergen Alt a 1. Allergy, asthma & immunology research, 8(5), 428-437.
- Chruszcz, M., Chapman, M. D., Osinski, T., Solberg, R., Demas, M., Porebski, P. J., … & Minor, W. (2012). Alternaria alternata allergen Alt a 1: a unique β-barrel protein dimer found exclusively in fungi. Journal of Allergy and Clinical Immunology, 130(1), 241-247.

Get Special Gift: Industry-Standard Mold Removal Guidelines
Download the industry-standard guidelines that Mold Busters use in their own mold removal services, including news, tips and special offers:

Written by:
Dusan Sadikovic
Mycologist – MSc, PhD
Mold Busters
Fact checked by:
Michael Golubev
General Manager
Mold Busters
